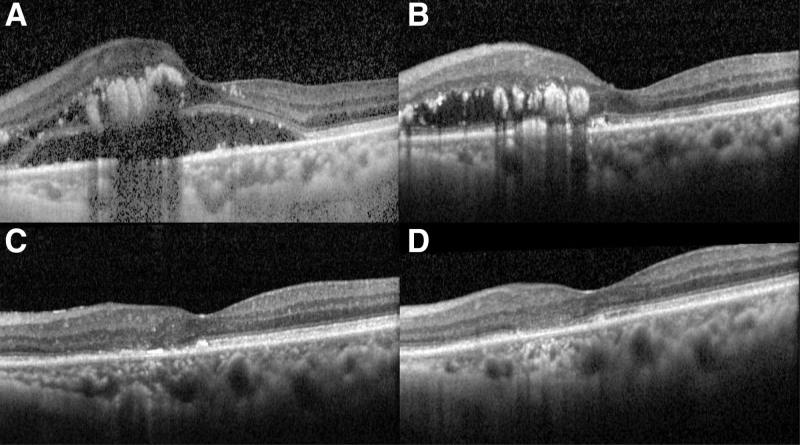

玻璃体腔内注射阿柏西普成功治疗老年特发性视网膜血管炎、动脉瘤和神经视网膜炎(IRVAN)综合征相关黄斑水肿和渗出:一例报告。
Successful treatments of idiopathic retinal vasculitis, aneurysms, and neuroretinitis (IRVAN) syndrome-related macular edema and exudation by intravitreal aflibercept injection in a senile patient: A case report.
机构信息
Department of Ophthalmology, China Medical University Hospital, China Medical University, Taichung, Taiwan.
Department of Ophthalmology, Changhua Christian Hospital, Changhua, Taiwan.
出版信息
Medicine (Baltimore). 2024 Sep 27;103(39):e39768. doi: 10.1097/MD.0000000000039768.
RATIONALE
The prevalence of idiopathic retinitis, vasculitis, aneurysms, and neuroretinitis (IRVAN) syndrome is <1/1,000,000, and it tends to occur in young women. Panretinal photocoagulation, focal laser photocoagulation, peripheral cryopexy, vitrectomy, and corticosteroid therapy are the traditional treatments. We reported a case of a senile patient with IRVAN syndrome who presented with severe exudation in both eyes and macular edema in the left eye, successfully treated by serial intravitreal aflibercept injections.
PATIENT CONCERNS
A 77-year-old Taiwanese woman complained of progressive blurred vision in the left eye and ocular examinations revealed a visual acuity of 20/125 in the left eye.
DIAGNOSIS
Indirect fundoscopy and fluorescein angiography showed bilateral multiple aneurysms, vasculitis, optic nerve staining, and neovascularizations. In addition, optical coherence tomography demonstrated macular edema with subretinal fluid and exudations in the left eye.
INTERVENTIONS
Monthly intravitreal injections of antivascular endothelial growth factor with aflibercept 2.0 mg were administered in the left eye.
OUTCOMES
The visual acuity in the left eye improved to 20/50 after 18 months of treatment. Macular edema and subretinal fluid regressed. Furthermore, vessel leakage and optic disc staining also improved.
LESSONS
This case is the first to demonstrate successful treatment of IRVAN syndrome-related central macular edema and exudations, in the absence of neovascularization, using a series of intravitreal aflibercept injections as monotherapy.
背景
特发性视网膜炎、血管炎、动脉瘤和神经视网膜炎(IRVAN)综合征的患病率<1/1000000,且常发生于年轻女性。全视网膜光凝、局灶性激光光凝、周边冷冻、玻璃体切除术和皮质类固醇治疗是传统的治疗方法。我们报告了一例 IRVAN 综合征老年患者,双眼有严重渗出,左眼有黄斑水肿,通过连续玻璃体内注射阿柏西普成功治疗。
患者关注
一名 77 岁台湾女性因左眼视力渐进性模糊而就诊,左眼视力检查结果为 20/125。
诊断
间接眼底镜和荧光素血管造影显示双侧多发性动脉瘤、血管炎、视神经染色和新生血管。此外,光学相干断层扫描显示左眼黄斑水肿伴视网膜下液和渗出。
干预
左眼每月玻璃体内注射抗血管内皮生长因子 2.0mg 的阿柏西普。
结果
治疗 18 个月后,左眼视力提高至 20/50。黄斑水肿和视网膜下液消退。此外,血管渗漏和视盘染色也有所改善。
结论
本例是首例在无新生血管的情况下,通过一系列玻璃体内注射阿柏西普单药治疗成功治疗 IRVAN 综合征相关中心性黄斑水肿和渗出的病例。